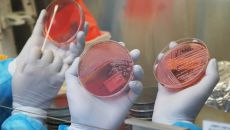

언론사별 뉴스
2026
일
월
화
수
목
금
토
-

윤석열 '체포 방해' 1심 징역 5년 선고
(서울=뉴스1) 이광호 기자 = 16일 오후 서울역에서 시민들이 체포 방해와 국무위원 심의권 침해 등 혐의로 기소된 윤석열 전- 17시간전
- 뉴스1
-

기은수, 새벽엔터와 전속계약…이문식·하준과 한솥밥
(서울=뉴스1) 안태현 기자 = 배우 기은수가 새벽엔터테인먼트와 전속계약을 체결하며 새로운 출발을 알렸다. 16일 새벽엔터테인- 17시간전
- 뉴스1
-

거수경례하는 이재명 대통령
(서울=뉴스1) 허경 기자 = 이재명 대통령이 16일 청와대 본관에서 열린 3성 장군 진급·보직 신고 및 수치 수여식에서 거수- 17시간전
- 뉴스1
-

尹 '체포방해·국무위원 심의권 침해' 1심 징역 5년 선고(2보)
(서울=뉴스1) 이세현 유수연 기자 = 체포 방해와 국무위원 심의권 침해 등 혐의로 기소된 윤석열 전 대통령이 1심에서 징역- 17시간전
- 뉴스1
-

이재명 대통령, 박성제 특수전사령관 삼정검 수치 수여
(서울=뉴스1) 허경 기자 = 이재명 대통령이 16일 청와대 본관에서 열린 3성 장군 진급·보직 신고 및 수치 수여식에서 박성- 17시간전
- 뉴스1
-
일주일 새 노로바이러스 환자 548명 발생…5년 내 최대
(서울=뉴스1) 조유리 기자 = 지난 일주일 새 노로바이러스 감염증 환자는 548명으로, 최근 5년 내 최고 많이 발생했다.- 17시간전
- 뉴스1
-

'애둘맘' 에바, 육감적 수영복 자태…운동으로 만든 라인[N샷]
(서울=뉴스1) 윤효정 기자 = 방송인 에바 포피엘이 탄탄한 몸매를 자랑했다. 에바는 16일 인스타그램에 "즐거웠어 코타키나발- 17시간전
- 뉴스1
-

전남도, 장성·강진에 AI 데이터센터 구축
(무안=뉴스1) 전원 기자 = 전남도는 16일 장성군·강진군, 민간 참여 기관과 함께 AI 데이터센터 구축을 위한 업무협약을- 17시간전
- 뉴스1
-

예산 당진대전고속도로 달리던 SUV에 불…차량 전소
(예산=뉴스1) 최형욱 기자 = 16일 오전 9시 51분께 충남 예산 당진대전고속도로 당진 방향 수덕사IC 진출로 갓길에서 주- 17시간전
- 뉴스1
-

'알파고 아버지' 딥마인드 허사비스 "中 AI, 美와 불과 몇달 격차"
(서울=뉴스1) 윤다정 기자 = 구글 딥마인드의 데미스 허사비스 최고경영자(CEO)가 중국의 인공지능(AI) 모델 수준이 미국- 17시간전
- 뉴스1
-

'오인간' 로몬 "김혜윤과 촬영하며 왜 '로코 퀸'인지 느껴"
(서울=뉴스1) 김민지 기자 = '오늘부터 인간입니다만' 로몬이 김혜윤을 칭찬했다. 16일 오후 서울 양천구 목동서로 SBS- 17시간전
- 뉴스1
-

B형 독감 증가세…"백신 미접종 고위험군, 지금이라도 예방접종"
(서울=뉴스1) 강승지 기자 = 최근 감소세였던 인플루엔자(계절 독감)가 소아 청소년을 중심으로 소폭 증가하고 B형 인플루엔자- 17시간전
- 뉴스1
-

“TSMC 랠리로 코스피 11일 연속 신고가 행진”-블룸버그
(서울=뉴스1) 박형기 기자 = 세계 최대 파운드리(위탁 생산) 업체 TSMC 발 반도체주 랠리로 한국의 코스피가 또다시 사상- 17시간전
- 뉴스1
-

[속보] 尹 '체포방해·국무위원 심의권 침해' 1심 징역 5년 선고
sh@news1.kr Copyright ⓒ 뉴스1. All rights reserved. 무단 전재 및 재배포, AI학습 이용- 17시간전
- 뉴스1
-

건보공단, '2025년도 연간지급내역 통보서' 제공
(서울=뉴스1) 구교운 기자 = 국민건강보험공단은 병·의원, 약국, 건강검진기관, 노인장기요양기관 등 요양기관의 세무신고 편의- 17시간전
- 뉴스1

